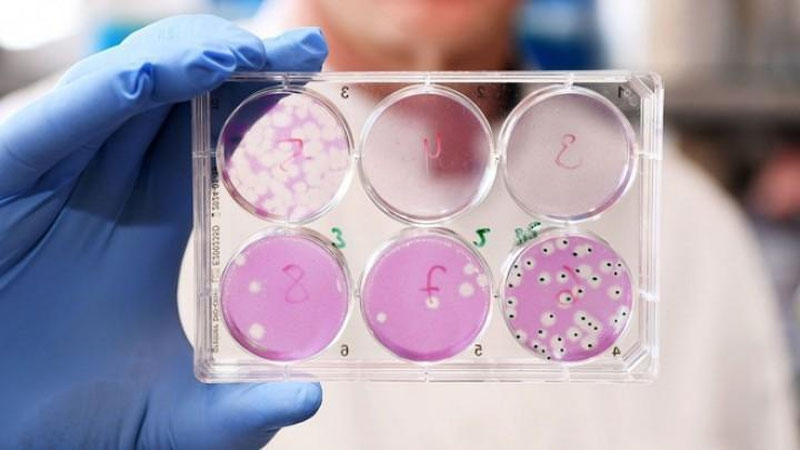

Хабарингиз бор, аввалроқ халқаро экспертлар “омикрон”нинг янги версиялари дунё бўйлаб кенг тарқала бошлаганидан хавотир билдиришган эди. BА.2.12.1 субварианти — шулардан бири.
Мазкур мутациянинг ўчоғи Нью-Йорк шаҳри ҳисобланади. У бутун Қўшма Штатларни шиддат билан “забт” этмоқда. Ҳатто мамлакатнинг қатор штатларида аллақачон доминантга айланиб улгурган.
Хўш, янги вариант нега мутахассисларни бу қадар ташвишлантиряпти? ССВ матбуот хизмати бу борадаги маълумотларни тақдим этди.
Маълум қилинишича, BА.2.12.1 бошқа мутацияларга нисбатан антитаначаларга осонроқ “чап бериш” хусусиятига эга. Қолаверса, юқувчанлиги, трансмиссивлиги “омикрон”нинг BA.2 версияга нисбатан 23-27 фоиз юқори.
Бу эса касалликдан ҳимояланиш бир мунча қийинлашиши ва коронавирусга чалинган беморлар сони сезиларли даражада ортишига сабаб бўлиши мумкин. Содда қилиб айтганда, олимлар дунёда пандемиянинг янги тўлқини бошланишидан ташвишда!
Маълумотларга кўра, BА.2.12.1 субварианти шу кунгача дунёнинг камида 23 мамлакатида қайд этилган ва у жаҳон бўйлаб ёйиляпти.
Жумладан, янги штамм кеча илк бор сайёрамиз аҳолисининг қарийб бешдан бир қисми яшайдиган Хитой давлатида ҳам қайд этилди. Аниқланишича, касаллик Гуанчжоу шаҳрига Кения мамлакатидан келган беморда рўйхатга олинган. Гарчи у 14 кунлик карантинга олинган бўлса-да, янги вирус турини бошқа беморлар ҳам юқтириб олган бўлиши эҳтимоли мавжуд.
Жаҳон соғлиқни сақлаш ташкилоти ана шундай мураккаб эпидемиологик вазиятдан келиб чиқиб, “омикрон”нинг олти янги мутацияси — BА.4 ва BА.5, BА.2.12.1, BА.2.9.1, BА.2.11 ва BА.2.13 субверсияларини “VOC-LUM” тоифасига киритиб, ўз кузатуви остига олди.